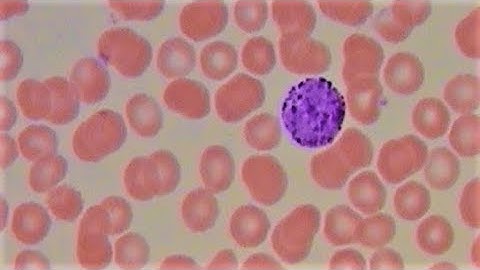
Visualization of blood and the cells it contains

⬇ DOWNLOAD NOW
Jika muncul iklan pop-up, tutup lalu klik tombol kembali
Download lagu CVPR 2019 - 1 - Red blood cell image generation for data augmentation using CGAN secara gratis hanya untuk keperluan promosi. Dukung artis favorit kamu dengan membeli musik original di iTunes atau platform resmi lainnya.
 Research at NVIDIA: Medical Image Synthesis for Data Augmentation and Anonymization Using GANs
Research at NVIDIA: Medical Image Synthesis for Data Augmentation and Anonymization Using GANs Advancing deep medical image segmentation with adversarial data augmentation | Chen Chen
Advancing deep medical image segmentation with adversarial data augmentation | Chen Chen 3D Common Corruptions and Data Augmentation (CVPR 2022, Oral)
3D Common Corruptions and Data Augmentation (CVPR 2022, Oral) Immunology wars: A billion antibodies
Immunology wars: A billion antibodies MedAI Session 30: GANs in Medical Image Synthesis, Translation, and Augmentation | Jason Jeong
MedAI Session 30: GANs in Medical Image Synthesis, Translation, and Augmentation | Jason Jeong Holographic Blood®
Holographic Blood® Visualization of blood and the cells it contains
Visualization of blood and the cells it contains GAN-Based Data Augmentation and Anonymization for Skin-Lesion Analysis: A Critical Review (Full)
GAN-Based Data Augmentation and Anonymization for Skin-Lesion Analysis: A Critical Review (Full)